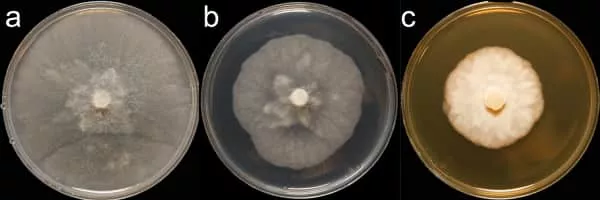

Phytophthora Capsici
| Use attributes for filter ! | |
| Scientific name | Phytophthora capsici |
|---|---|
| Higher classification | Phytophthora |
| Phylum | Heterokontophyta |
| Order | Peronosporales |
| Rank | Species |
| Family | Peronosporaceae |
| Date of Reg. | |
| Date of Upd. | |
| ID | 1218922 |
About Phytophthora Capsici
Phytophthora capsici is an oomycete plant pathogen that causes blight and fruit rot of peppers and other important commercial crops. It was first described by L. Leonian at the New Mexico State University Agricultural Experiment Station in Las Cruces in 1922 on a crop of chili peppers. In 1967, a study by M. M.